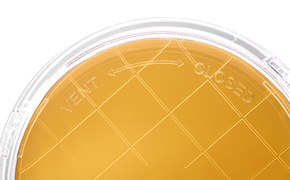

Contact Plates for Personnel and Surface Monitoring

Our ready-to-use contact plates can be used for environmental monitoring of surfaces in critical clean rooms and isolators (ICR series) as well as in non-critical areas (RT series). To minimize the risk of contamination, our contact plates are produced in clean rooms. They can be stored at room temperature and the ICRplus/RTplus versions are lockable and can be safely transported for incubation under aerobic, microaerophilic or anaerobic conditions.
Our contact plates contain either Tryptic Soy Agar (TSA), Sabouraud Dextrose Agar (SDA) or a non-animal, vegetable peptone media for minimal risk of BSE/TSE contamination. The plates are available supplemented with neutralizers of a wide range of disinfectants or β-lactam antibiotics for monitoring sanitized, dry surfaces. Neutralizers such as lecithin (L), Tween 80 (T), histidine (H) and sodium thiosulfate (Th/Thio) can inactivate residues of disinfectants, a wide range of which are used worldwide. Plates supplemented with cephalosporinase or penicillinase are used to inactivate a wide spectrum of β-lactam antibiotics.
Customer Feedback
Olga Defterigou, Senior Microbiology Lab Manager at Elpen Pharmaceutical Co. Inc.:
"The culture medium of contact plates has excellent growth promoting properties. The wrap is superior to others, durable with easy opening. The desiccant greatly limits the creation of moisture. A gold standard for surface testing of grade A/B areas and gowning testing of aseptic operators."

Gamma-irradiated contact plates – ICR and ICR plus plates for isolators and critical cleanrooms
Gamma-irradiated and triple bagged contact plates are suitable for use in critical cleanrooms, RABS and isolators. They can be used for surface and personnel monitoring, but also for active air monitoring with MAS® air samplers. We offer two versions in a non-lockable (ICR) and lockable (ICR plus) format. The ICR plus version is furthermore suitable for anaerobic monitoring.
Secure and reliable
- CLOSED- or VENT-Closure: safe transport and flexible incubation conditions
- 2D Data matrix barcode on each plate for secure identification of each plate
- Transparent, VHP-impermeable triple-sleeve packaging for safe transportation in cleanrooms (ISO 5) and isolators
- Produced in cleanrooms and gamma-irradiated in final packaging to minimize risk of contamination

Convenient
- Storage at room temperature
- Long shelf life: allows fewer incoming goods controls
- SDA in pink plates: easily distinguish between TSA and SDA
Flexible
- Neutralizer supplements for use in isolators after VHP decontamination
- Broad range of formulations: total bacterial count, yeast and mold even in the presence of antimicrobial residues such as sanitizers or disinfectants or beta-lactam-antibiotics
- Media with non-animal origin available: minimizing the risk of BSE contamination
NEW - TSA LTHThio contact ICR/ICR+
The new TSA (Tryptic soy agar) media including the four neutralizers lecithin (L), Tween 80 (T), Histidine (H) and sodium Thiosulfate (Thio) provides additional unique features:
- 12 months shelf-life – decrease the frequencies of incoming controls – cost reduction
- Add-ons to the certificate of analyses:
- verification of anaerobic growth for lockable plates
- functionality check of individual 2-D matrix code
- disinfectant test part of the release testing
Non-irradiated contact plates - RT and RT plus plates for monitoring in controlled areas

Our RT and RTplus contact plates are designed for microbial monitoring of dry surfaces such as floors, walls, textiles and working garments of personnel in controlled areas.
Formulations are available for determining total aerobic microbial count (Tryptic Soy Agar = Casein Soya Bean Digest Agar = TSA or Plate Count Agar= PCA), yeast and mold count and total count for specified microorganisms. When monitoring sanitized surfaces plates neutralizers such as lecithin (L), tween 80 (T); histidine (H) and sodium thiosulfate (Th/Thio) can inactivate a wide range of disinfectants.
- Secure & Reliable: 2D Data matrix barcode on each plate: Safe and paperless identification of individual plates
- Convenient: Room temperature stability: Storable at site of use
Lid in CLOSED Position
- Safe transportation from sampling area to the lab
- Recommended for prolonged aerobic incubation period
Lid in VENT Position
- Mandatory for incubation under microaerophilic or anaerobic conditions
- Suitable also for short-term incubation under aerobic conditions
Related Materials
To continue reading please sign in or create an account.
Don't Have An Account?